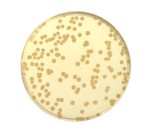

Sugar Free Agar
- Formato: 10 x 90 mm Petri
- Codice: TMB_SFA_P90_10
- Tecnologia: Terreni e test di conferma ISO
- Applicazione: Analisi microbiologiche
- Tag/filtro:
Lo Sugar Free Agar viene utilizzato per il conteggio dei batteri Gram-negativi psicrotrofi e mesofili. Il prodotto non è destinato alluso in diagnostica umana.
- Formato: 10 x 90 mm Petri
- Codice: TMB_SFA_P90_10
- Tecnologia: Terreni e test di conferma ISO
- Applicazione: Analisi microbiologiche
- Tag/filtro:

